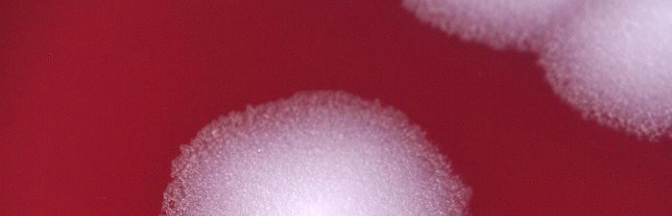

No themed coverage this week, sadly. However, we’ve got stories covering the Federal fight against antibiotic resistance, ISIS airstrikes, and super mosquitoes in Florida. All this in addition to stories you may have missed.
Have a fun Super Bowl Sunday (go team!) and a safe and healthy week!
Obama Asking Congress to Nearly Double Funding to Fight Antibiotic Resistance to $1.2 Billion
One of The White House’s goals for 2015 was to combat growing antibiotic resistance through research into new antibiotics and efforts to prevent the over prescription of these vital drugs. President Obama is requesting that Congress add additional funding to this fight, bringing the total to $1.2 billion. The funding will be a start, but there are many other things that can happen in order to fight this extremely important problem.
U.S. News & World Report—“The Centers for Disease Control and Prevention says more than 23,000 Americans die every year from infections that can withstand some of the best antibiotics. The World Health Organization said last year that bacteria resistant to antibiotics have spread to every part of the world and might lead to a future where minor infections could kill.”
Air Strike Kills IS ‘Chemical Weapons Expert’
News came Saturday morning that U.S. airstrikes in Iraq last week killed a mid-level Islamic State militant who specialized in chemical weapons. Killed on January 24, Abu Malik had worked at Saddam Hussein’s Muthana chemical weapons production facility before joining Al-Qaeda in Iraq in 2005.
Radio Free Europe/Radio Liberty—“Officials say his death could “temporarily degrade” the group’s ability to produce and use chemical weapons. Coalition air strikes have pounded the Mosul area over the past week [and] The U.S.-led coalition has carried out more than 2,000 air raids against IS militants in Syria and Iraq since August 8.”
Millions of Genetically Modified Mosquitoes Could Fight Disease in Florida
On January 11, we had a small note about the possibility of genetically modified mosquitos controlling diseases like chikungunya and dengue, but this week coverage on this issue absolutely exploded! British biotech firm Oxitec plans to release millions of genetically modified mosquitos in Florida to control the existing population and help control the spread of these diseases. The A. Aegypti species of mosquito is extremely prevalent in Florida and recently has become resistant to most chemical pesticides. Residents, of course, are up in arms over the potential release of this “mutant mosquito”.
The Weather Channel—“Technology similar to this is already in use in Florida and other states, Entomology Today points out. Sterile Insect Technique (SIT) employs a similar technique, sterilizing insects so that when they mate, no offspring are produced. “Florida spends roughly $6 million a year using SIT to prevent Mediterranean fruit fly infestations, while California spends about $17 million a year,” Entomology Today wrote.”
Stories You May Have Missed
- According to the WHO, polio immunization rates in Syria are now close to their pre-war level. Prior to 2011, the rate was nearly 90%, but had fallen to around 50% as conflict interrupted vaccination campaigns.
- As Ebola appears to be winding down in Liberia, life is beginning to return to normal, MSF warns not to lose vigilance, though, because a single new case could set off another outbreak. In reflection of events in West Africa, the WHO is looking towards repairing their reputation and scientists are evaluating strategic vaccine stockpiles.
- Russia is ending their nuclear cooperation with the U.S. which Washington Post Editorial Board says is “Vladimir Putin…peevishly shooting his nation in the foot”
- With funding from DTRA, scientists have developed a thin film which is able to detect chemical warfare agents (CWAs). The films change color when exposed to CWAs which will be critical for real-time detection.
- According to a study conducted by the London School of Hygiene and Tropical Medicine and the University of Michigan, Tamiflu (oseltamivir) is effective against seasonal flu. The research indicated that Tamiflu cuts the length of the disease by one day and significantly reduces the chance of life-threatening complications.
Image Credit: Wikimedia Commons